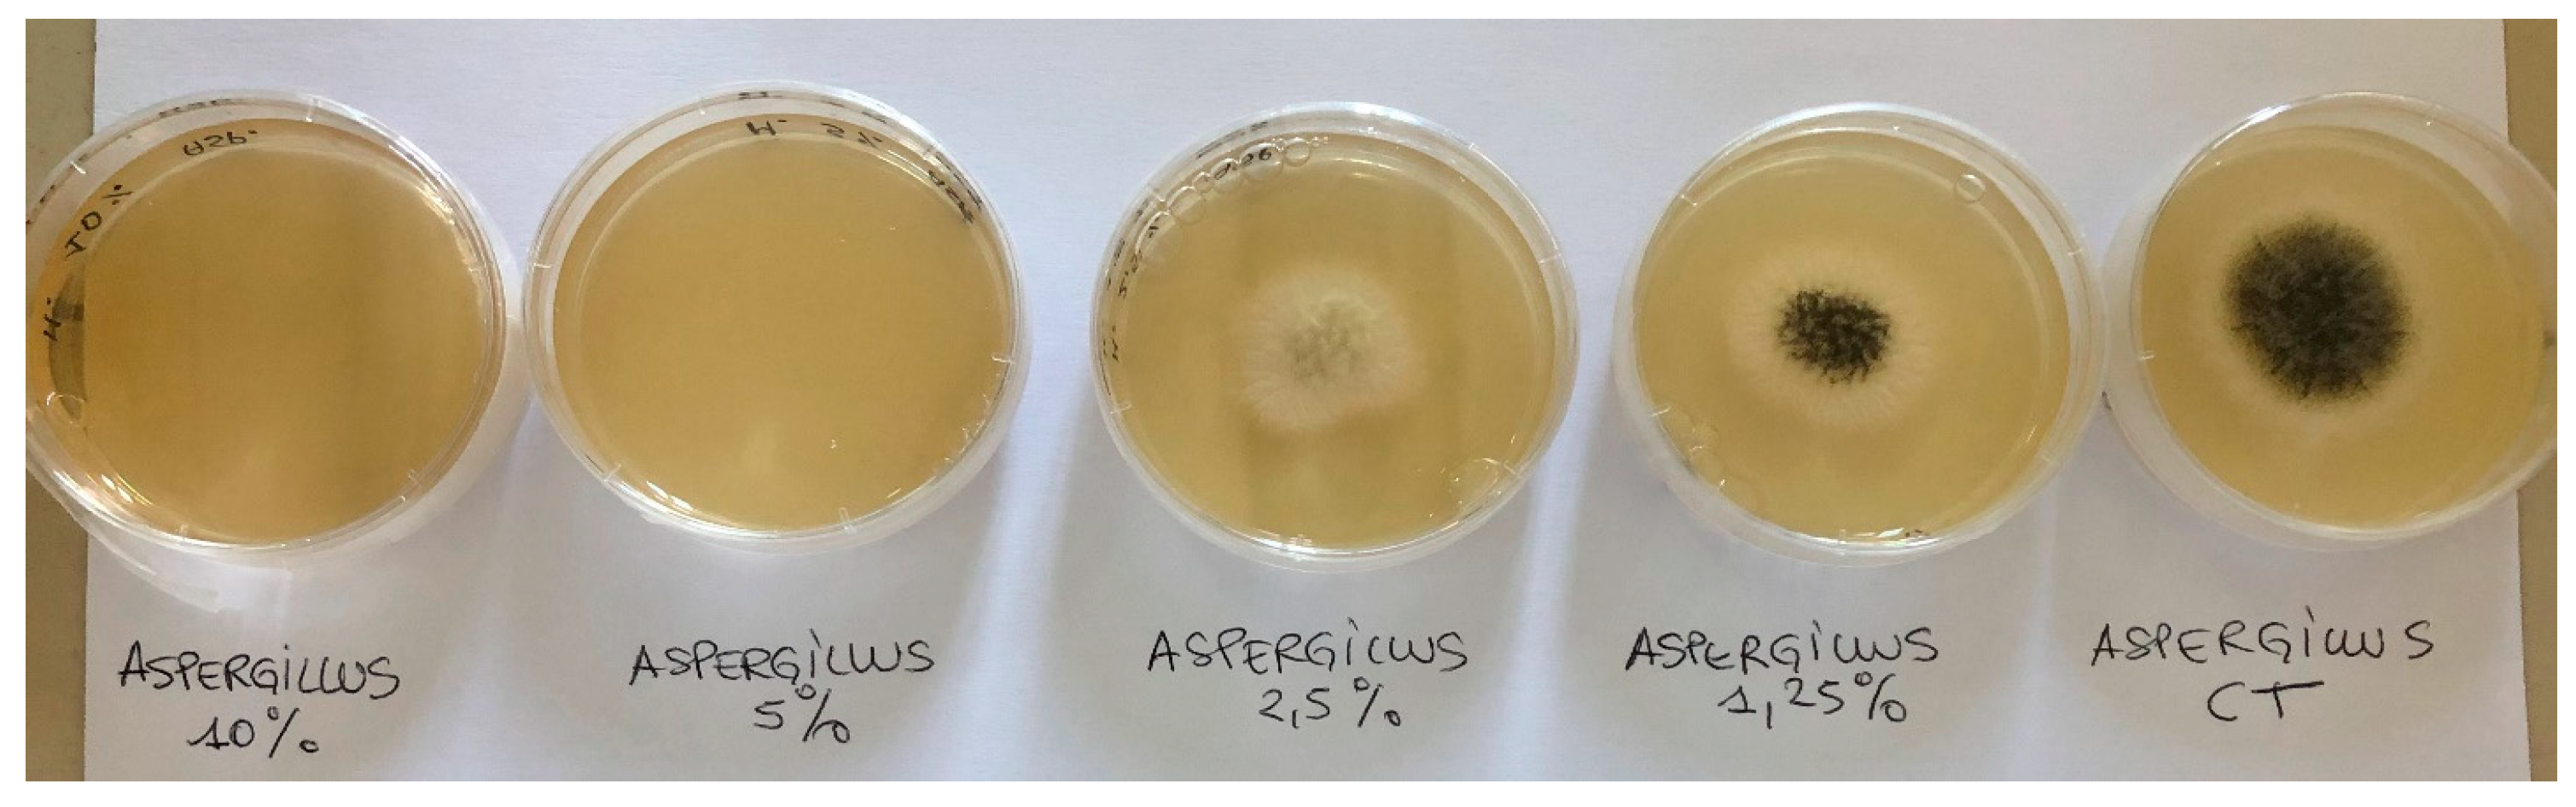
Applsci 14 07761 g002

A Radish Root Ferment Filtrate for Cosmetic Preservation: A Study of Efficacy of Kopraphinol
Abstract
1. Introduction
2. Materials and Methods
2.1. Materials
2.2. Antibacterial Activity of Kopraphinol and Methylparaben
2.3. Antifungal Activity of Kopraphinol and Methylparaben
2.4. Thermal Stability
- -
- exposure to 50 °C in a thermostatic water bath for 1 h (K50);
- -
- exposure to flowing steam at 100 °C in an autoclave for 1 h (K100);
- -
- freezing at −80 °C for 24 h and subsequent thawing (K*).
2.5. Contact Time (Killing Time)
2.6. Challenge Test
3. Results
3.1. Antimicrobial Activity
3.2. Thermal Stability
3.3. Killing Time
3.4. Challenge Test
4. Discussion
Author Contributions
Funding
Institutional Review Board Statement
Informed Consent Statement
Data Availability Statement
Conflicts of Interest
References
- European Commission. Regulation (EC) No 1223/2009 of the European Parliament and of the Council of 30 November 2009 on Cosmetic Products; Official Journal of the European Union L342/59; Publications Office of the European Union: Luxembourg, 2009. [Google Scholar]
- Giorgio, A.; Miele, L.; De Bonis, S.; Conforti, I.; Palmiero, L.; Guida, M.; Libralato, G.; Aliberti, F. Microbiological stability of cosmetics by using Challenge Test procedure. J. Pure App. Microbiol. 2018, 12, 23–28. [Google Scholar] [CrossRef]
- SCCS (Scientific Committee on Consumer Safety). Appendix 9: Guidelines on microbial quality of the finished cosmetic product. In The SCCS Notes of Guidance for the Testing of Cosmetic Ingredients and Their Safety Evaluation; 12th revision; SCCS: Brussels, Belgium, 2023; pp. 148–150. [Google Scholar]
- Halla, N.; Fernandes, I.P.; Heleno, S.A.; Costa, P.; Boucherit-Otmani, Z.; Boucherit, K.; Rodrigues, A.E.; Ferreira, I.C.F.R.; Barreiro, M.F. Cosmetic preservation: A review on present strategies. Molecules 2018, 23, 1571. [Google Scholar] [CrossRef] [PubMed]
- Nowak, K.; Jablónska, E.; Ratajczak-Wrona, W. Controversy around parabens: Alternatives strategies for preservative use in cosmetics and personal care products. Environ. Res. 2021, 198, 110488. [Google Scholar] [CrossRef] [PubMed]
- European Commission. Regulation (EU) N° 1004 (2014) of 18 September 2014 Amending Annex V to Regulation (EC) N° 1223/2009 of the European Parliament and of the Council on Cosmetic Products; Official Journal of the European Union L282/5; Publications Office of the European Union: Luxembourg, 2009. [Google Scholar]
- Martins, A.M.; Marto, J.M. A sustainable life cycle for cosmetics: From design and development to post-use phase. Sustain. Chem. Pharm. 2023, 35, 101178. [Google Scholar] [CrossRef]
- Paramita, S.; Kusuma, I.W.; Sulistioadi, Y.B.; Kiswanto. Environmental and Safety Aspects of bio-based Cosmetics in Indonesia. In Biomass-Based Cosmetics; Arung, E.T., Fatriasari, W., Kusuma, I.W., Kuspradini, H., Shimizu, K., Kim, Y.-U., Azelee, N.I.W., Edis, Z., Eds.; Springer: Singapore, 2024; pp. 545–568. [Google Scholar] [CrossRef]
- Poddebniak, P.; Kalinowska-Lis, U. A survey of preservatives used in cosmetic products. Appl. Sci. 2024, 14, 1581. [Google Scholar] [CrossRef]
- Kopraphinol (Radish Root Ferment Filtrate). Available online: https://www.kumarorganic.net/kopraphinol/ (accessed on 8 July 2024).
- Elshikh, M.; Ahmed, S.; Funston, S.; Dunlop, P.; McGaw, M.; Marchant, R.; Banat, I.M. Resazurin-based 96-well plate microdilution method for the determination of minimum inhibitory concentration of biosurfactants. Biotechnol. Lett. 2016, 38, 1015–1019. [Google Scholar] [CrossRef] [PubMed]
- Therese, K.L.; Bagyalakshmi, R.; Madhavan, H.N.; Deepa, P. In-vitro susceptibility testing by agar dilution method to determine the minimum inhibitory concentrations of amphotericin B, fluconazole and ketoconazole against ocular fungal isolates. Ind. J. Med. Microbiol. 2006, 24, 273–279. [Google Scholar] [CrossRef]
- Juliano, C.; Mattana, A.; Usai, M. Composition and in vitro Antimicrobial Activity of the Essential Oil of Thymus herba-barona Loisel growing wild in Sardinia. J. Essent. Oil Res. 2000, 12, 516–522. [Google Scholar] [CrossRef]
- Siegert, W. Comparison of microbial challenge testing methods for cosmetics. Househ. Pers. Care Today 2013, 8, 32–39. [Google Scholar]
- Council of Europe; European Directorate for the Quality of Medicines and Healthcare (Eds.). Chapter 5.1.3. Efficacy of antimicrobial preservation. In European Pharmacopeia, 7th ed.; Council of Europe: Strasbourg, France, 2011. [Google Scholar]
- Juliano, C.; Gavini, E.; Giunchedi, P.; Magrini, G.A. Evaluation of Manuka honey as an adjuvant antimicrobial preservative in a O/A emulsion. J. Appl. Cosmetol. 2016, 34, 87–98. [Google Scholar]
- Pérez-Rivero, C.; Lòpez-Gòmez, J.P. Unlocking the potential of fermentation in cosmetics: A review. Fermentation 2023, 9, 463. [Google Scholar] [CrossRef]
- Majchrzak, W.; Motyl, I.; Smigielski, K. Biological and cosmetical importance of fermented raw material: An overview. Molecules 2022, 27, 4845. [Google Scholar] [CrossRef] [PubMed]
- Romanowski, P.; Schueller, R. Definition and principles of multifunctional cosmetics. In Multifunctional Cosmetics, 1st ed.; Schueller, R., Romanowski, P., Eds.; Taylor & Francis: Boca Raton, FL, USA, 2001; pp. 1–11. [Google Scholar]
- Cosmetic Ingredient Review. Safety Assessment of Radish Root-Derived Ingredients as Used in Cosmetics. 2022. Available online: https://cir-safety.org/sites/default/files/Radish.pdf (accessed on 2 July 2024).
- Pinto, D.; Ciardiello, T.; Franzoni, M.; Pasini, F.; Giuliani, G.; Rinaldi, F. Effect of commonly used cosmetic preservatives on skin resident microflora dynamics. Sci. Rep. 2021, 11, 8695. [Google Scholar] [CrossRef] [PubMed]

| Microorganisms | Kopraphinol (vol/vol) | Methylparaben (wt/vol) |
|---|---|---|
| Escherichia coli (ATCC 8739) | 0.78 ± 0.00% (6.25 ± 0.00%) | 0.2 ± 0.00% (0.2 ± 0.00%) |
| Staphylococcus aureus (ATCC 6538) | 1.56 ± 0.00% (12.5 ± 0.00%) | 0.2 ± 0.00% (0.2 ± 0.00%) |
| Pseudomonas aeruginosa (ATCC 9027) | 6.25 ± 0.00% (6.25 ± 0.00%) | 0.2 ± 0.00% (0.2 ± 0.00%) |
| Candida albicans (ATCC 10231) | 1.56 ± 0.00% (3.13 ± 0.00%) | 0.05 ± 0.00% (0.05 ± 0.00%) |
| Candida spp. (from rectal swab) | 3.13 ± 0.00% (6.25 ± 0.00%) | n.d. |
| Candida spp. (from throat swab) | 1.56 ± 0.00% (1.56 ± 0.00%) | n.d |
| Candida spp. (from vaginal swab) | 1.56 ± 0.00% (6.25 ± 0.00%) | n.d. |
| Candida spp. (from mucosa of the cheek) | 1.56 ± 0.00% (3.13 ± 0.00%) | n.d. |
| Aspergillus brasiliensis (ATCC 16404) | 5.00 ± 0.00% | 0.1 ± 0.00% |
| Penicillium rubens (ATCC 9179) | 5.00 ± 0.00% | n.d. |
| E. coli (ATCC 8739) | P. aeruginosa (ATCC 9027) | S. aureus (ATCC 6538) | C. albicans (ATCC 10231) | |
|---|---|---|---|---|
| MIC K | 0.78 ± 0.00% | 6.25 ± 0.00% | 1.56 ± 0.00% | 1.56 ± 0.00% |
| MIC K50 | 0.78 ± 0.00% | 6.25 ± 0.00% | 1.56 ± 0.00% | 1.56 ± 0.00% |
| MIC K100 | 0.78 ± 0.00% | 6.25 ± 0.00% | 1.56 ± 0.00% | 1.56 ± 0.00% |
| MIC K* | 0.78 ± 0.00% | 6.25 ± 0.00% | 1.56 ± 0.00% | 1.56 ± 0.00% |
| STRAIN | Time 0 | 1 h | 2 h | 3 h |
|---|---|---|---|---|
| E. coli (ATCC 8739) | 100% | 30 ± 6.6% | 0.46 ± 0.25% | 0.17 ± 0.09% |
| P. aeruginosa (ATCC 9027) | 100% | 91.7 ± 7.6% | 33.3 ± 5.6% | 9.8 ± 4.5% |
| S. aureus (ATCC 6538) | 100% | 120.8 ± 7.7% | 141.7 ± 9.9% | 83.3 ± 7.5% |
| C. albicans (ATCC 10231) | 100% | 98.3 ± 8.7% | 84.5 ± 5.0% | 70.7 ± 10.5% |
| TIME | Eur. Ph. Criteria | Escherichia coli | Staphylococcus aureus | Pseudomonas aeruginosa | ||||||
|---|---|---|---|---|---|---|---|---|---|---|
| W | K | M | W | K | M | W | K | M | ||
| Day 2 | 2 | 0.01 | >5 | >5 | 0.209 | >5 | 0.017 | −1.438 | 4.828 | 1.216 |
| Day 7 | 3 | −0.138 | >5 | >5 | >5 | >5 | >5 | −2.885 | >5 | −1.924 |
| Day 14 | - | - | - | - | - | - | - | - | - | - |
| Day 28 | NI | >5 | >5 | >5 | >5 | >5 | >5 | −2.793 | >5 | −0.711 |
| TIME | Eur. Ph. Criteria | Candida albicans | Aspergillus brasiliensis | ||||
|---|---|---|---|---|---|---|---|
| W | K | M | W | K | M | ||
| Day 2 | 2 | −3.117 | >5 | 0 | 0 | >5 | 0.405 |
| Day 7 | 3 | −3.569 | >5 | 0.430 | 0 | >5 | 0.310 |
| Day 14 | - | - | - | - | - | - | - |
| Day 28 | NI | −3.944 | >5 | 2.964 | −0.109 | >5 | −0.182 |
Disclaimer/Publisher’s Note: The statements, opinions and data contained in all publications are solely those of the individual author(s) and contributor(s) and not of MDPI and/or the editor(s). MDPI and/or the editor(s) disclaim responsibility for any injury to people or property resulting from any ideas, methods, instructions or products referred to in the content. |
© 2024 by the authors. Licensee MDPI, Basel, Switzerland. This article is an open access article distributed under the terms and conditions of the Creative Commons Attribution (CC BY) license (https://creativecommons.org/licenses/by/4.0/).
Share and Cite
Juliano, C.C.A.; Magrini, G.A. A Radish Root Ferment Filtrate for Cosmetic Preservation: A Study of Efficacy of Kopraphinol. Appl. Sci. 2024, 14, 7761. https://doi.org/10.3390/app14177761
Juliano CCA, Magrini GA. A Radish Root Ferment Filtrate for Cosmetic Preservation: A Study of Efficacy of Kopraphinol. Applied Sciences. 2024; 14(17):7761. https://doi.org/10.3390/app14177761
Chicago/Turabian StyleJuliano, Claudia Clelia Assunta, and Giovanni Antonio Magrini. 2024. "A Radish Root Ferment Filtrate for Cosmetic Preservation: A Study of Efficacy of Kopraphinol" Applied Sciences 14, no. 17: 7761. https://doi.org/10.3390/app14177761
APA StyleJuliano, C. C. A., & Magrini, G. A. (2024). A Radish Root Ferment Filtrate for Cosmetic Preservation: A Study of Efficacy of Kopraphinol. Applied Sciences, 14(17), 7761. https://doi.org/10.3390/app14177761

